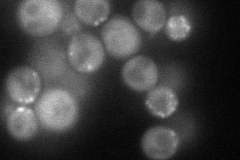
YNL106C
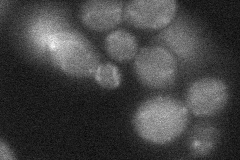
YNL106C
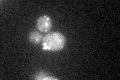
YNL106C

View description
Polyphosphatidylinositol phosphatase, dephosphorylates a number of phosphatidylinositols (PIs) to PI; involved in endocytosis; hyperosmotic stress causes translocation to actin patches; synaptojanin-like protein with a Sac1 domain
Localization:
Intensity:
Fold change:
Significance:
-
C’ GFP library in SD

punctate24.6 -
N' NOP1pr-GFP in SD
cytosol,punctate71.3848 -
N' TEF2pr-mCherry in SD

vacuole0 -
N' NATIVEpr-GFP in SD

punctate,bud neck25.6629 -
N' TEF2pr-VC and Cyto-VN in SD
punctate30.6545 -
C’ GFP library in SD+DTT
punctate22.540.91No -
C’ GFP library in SD+H2O2

punctate26.751.08No -
C’ GFP library in Starvation Media

punctate22.190.9No -
C’ GFP library on the background of Pup2-DaMP

punctate -
C’ GFP library on the background of CCT mutant

punctate28.15761.14436No
